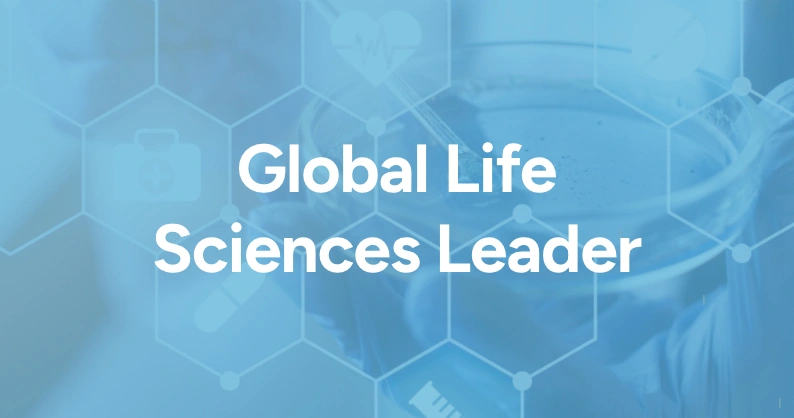
icon

End-to-End Revenue and Margin Optimization
Move from operational silos to full visibility and control of everything that affects your net margin.
The benefits you’ll see:
End-to-End Price Management
Price management and optimization from planning to execution. Drive prices, determine true profitability and manage complex pricing challenges.
The benefits you’ll see:

Pharma Success Stories
Enterprise software for

Planning
Develop strategic and tactical pricing plans to optimize revenue and margin.

Analytics
Benefit from greater operational control, provide contextual and real-time strategic analytics with deep data insights to drive profitability.

Price Management, Guidance & Optimization
Streamline end-to-end price management processes – from price planning to execution – aligning pricing models with sales strategies.

Regulatory Compliance
Automate the required government reportable pricing calculation and manage government rebate programs with a preconfigured solution.

Contract Management
Effectively manage direct, indirect and third-party contracts with on-invoice conditions, rebates, chargebacks, outcome-based and indication-based agreements, royalties, complex pricing and sales order promotions.

Global Payment Programs
Make rapid, secure global payments in over 135 currencies while reducing operational costs and increasing payee satisfaction and engagement.

Bids & Tenders
Manage tenders and bid responses from ingestion and analysis through award and execution.

Rebates
Execute all customer and trading partner rebate calculations, from simple per-unit rebates to performance-based scaled rebates and complex scenarios. When provided with the necessary data sources, the platform processes any logical arithmetic formula.

Gross-to-Net
Gain insight into your customer and product/brand profitability by capturing all elements of product and channel costs.

Chargebacks & Claim Management
Upload tools and standard EDI for data assimilation, utilizing user tools and workbenches to efficiently adjudicate claims and manage resubmission processes. Integrate workflows to enable seamless claim approval and settlement without data interfacing.

Accruals
Complete accrual capabilities from rate development and on-invoice GtN to financial postings and true-ups.

GPO & Membership Management
Retrieve group rosters and scrub content for market review. Load or update membership rosters to ensure proper contract eligibility.

Services
Professional services deliver your project on time and on budget. Our highly skilled experts bring deep industry expertise to the implementation and are specially trained to ensure deployment maximizes the value of our solutions.

Program Services >
Experts act as an extension of your team to deliver best-in-class program administration.

Solution Delivery >
Experts facilitate successful implementations, upgrades and post-production support.

Global Payments >
Obtain shorter payment cycles and higher security for claim audits, account reconciliation and more.

Business Advisory >
Consultants and services are a resource for efficiency and program effectiveness with analytical and problem-solving skills to help drive project success.

Training >
Global and local support teams and training programs offered online and in the classroom.
Pharma: Blogs

CMS And The New ASP Rules: What Pharma Manufacturers Need To Know
View Blog >

The Glocalization Imperative Why Life Sciences Must Master Global-Local Strategic Balance
View Blog >

Think Forward. Then Forward Again.
View Blog >

Beyond the AI Panacea: Real Solutions for Life Sciences
View Blog >

No Place to Hide: Shedding Light on Pharma Price Transparency
View Blog >

The Undertow Threatening Your Pricing Strategy: Parallel Trade
View Blog >
View More Blogs

Explore our Pharma Resources
Maximize revenue potential across your product lifecycle
Navigating complex pricing structures, provider agreements, GPO contracts, reimbursement challenges and evolving regulatory demands creates significant revenue management hurdles that impact your bottom line.
Is your organization equipped to address these industry-specific challenges with precision? We can help.
Submit this form to: